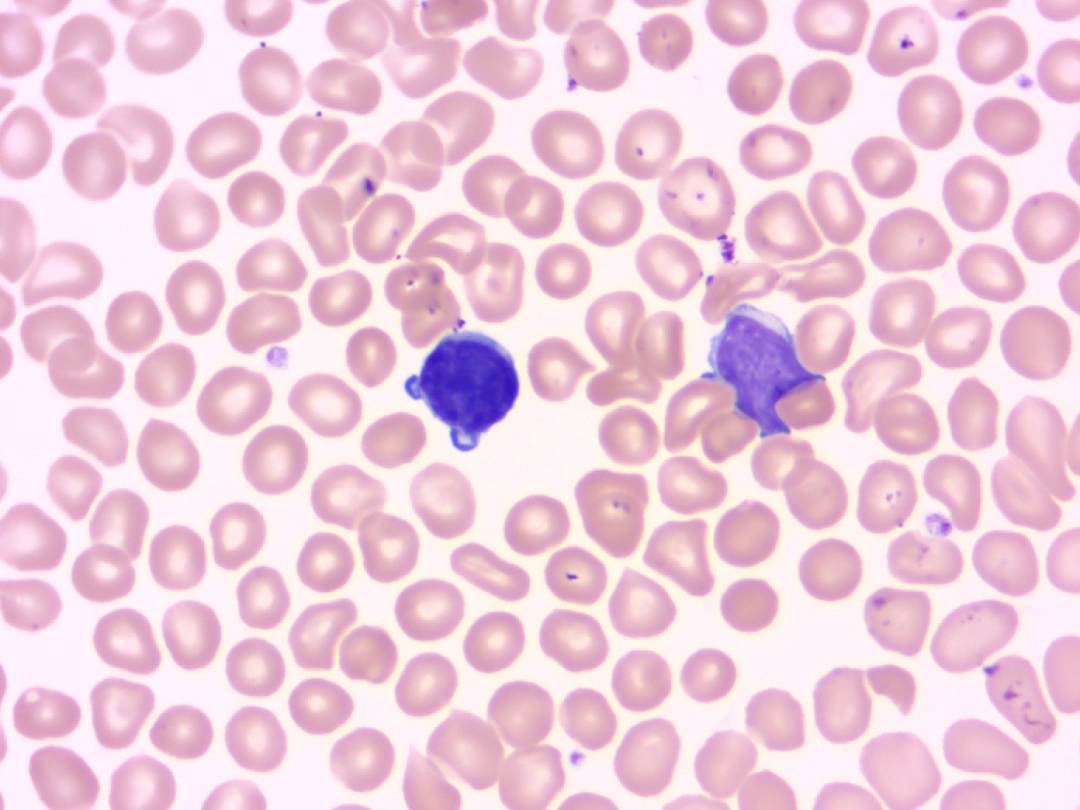
昆明市科协

宠物猫给很多家庭带来了欢乐,但是“养猫对孕妇和胎儿的健康不好”这个说法一直困扰着爱猫人士。养猫对孕妇的所有影响中,人们最担心的就是弓形虫感染。一边是对腹中宝宝健康的担忧,一边是不能舍弃陪伴多年有着深厚感情的猫咪。养猫与怀孕真的不能两全吗?
弓形虫是什么?
弓形虫很小,肉眼看不到,寄生于人和动物的细胞内,随血液流动,到达全身各部位。弓形虫有滋养体、包囊、裂殖体、配子体和卵囊5种不同形态,其中滋养体和包囊可存在于人体内,其余形态只能存在终宿主——猫和猫科动物身上。猫主要通过受感染的猫粪,以及捕食老鼠和鸟获得弓形虫感染。一般来讲,猫第一次感染弓形虫后会在感染的最初两周排出卵囊,卵囊在外界发育1~2天或更长时间才具有传染性。
弓形虫寄生于人和动物的细胞内
弓形虫对孕妇有什么危害?
免疫功能正常的成年人感染弓形虫多以隐性感染为主,只有10%~20%的患者有轻微感冒样症状。免疫力低下时,感染可引起发热、疲倦、淋巴结和肝脾大等。若女性在怀孕初期感染弓形虫,弓形虫可通过胎盘屏障,使胎儿发生弓形虫感染,从而导致流产、早产、死产,或者无脑儿、脑积水、小头畸形、小眼畸形、智力发育不全等畸形。
家有孕妇如何预防弓形虫感染呢?
1.注意饮食卫生
并非只有猫才能传播弓形虫,被污染的食物和环境都有可能。弓形虫主要经口传播,因此除了猫,未洗净的蔬菜水果、生的或半生的肉,以及被生肉污染的熟食都可能传播。因此,养成饭前、便后勤洗手的好习惯,能最大程度减少“病从口入”的机会。
2.科学养猫
猫进食了受感染的老鼠或鸟类可能会感染弓形虫。因此,猫要养在家里,喂熟食或成品猫粮,不让它们外出捕食。同时要注意日常生活卫生,猫排便后及时或24小时内清理,避免弓形虫的卵囊发育。怀孕最初3个月内,孕妇应严格与宠物保持距离,特别要避免接触猫的粪便,如果接触,接触后一定要认真洗手。

3.积极进行弓形虫检测
主人受孕前可以带猫做一次动物弓形虫检测。如果弓形虫抗体阳性,表明猫已感染弓形虫或有某种程度的免疫力;若弓形虫抗体为阴性,猫可能未被感染,但也要注意预防。
同时女性在备孕期间和怀孕早期可到医院做弓形虫常规检查,以减少胎儿先天性弓形虫病的发生。弓形虫IgM和IgG抗体如果均为阴性,表示孕妇没有感染过弓形虫,此时须做好感染的预防,并定期复查。如果IgG抗体阳性,提示既往发生过感染;但如果IgM抗体为阳性,就提示近期感染了弓形虫。
总之,虽然弓形虫可能会导致孕妇流产或胎儿畸形,但是我国弓形虫的发病率并不高,孕妇只要正确认识弓形虫,做到科学养猫、有效预防,是可以在怀孕期间养猫的。
来源:中华医学会